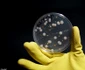
4 bijuterii contaminate 4 jpg jpeg
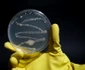
5 bijuterii contaminate 5 jpg jpeg
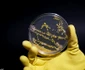
6 bijuterii contaminate 6 jpg jpeg

FOTO Cum te pot îmbolnăvi bijuteriile? Conţin mai multe bacterii decât un capac de toaletă

În urma unei cercetări, specialiştii unui magazin de bijuterii britanic au observat că podoabele purtate după doar o săptămână au avut peste 21.000 de bacterii, în timp ce inelele au găzduit cele mai multe specii de microbi.
Astfel, au fost analizate trei piese de bijuterii care au fost purtate timp de o săptămână. Cercetările efectuate de specialiştii în bijuterii şi ceasuri second-hand, de la Est1897, au constatat că inelul, ceasul şi cerceii adunaseră de 428 de ori mai mulţi germeni decât capacul de toaletă în doar şapte zile. În total, peste 21.000 de bacterii s-au manifestat pe bijuterii în decursul unei săptămâni, scrie Daily Mail.
Bijuteriile conţineau germeni de tipul stafilococ auriu rezistent la meticilină (MRSA) până la bacili difterici şi alte colonii bacteriene care pot provoca infecţii ale cavităţii bucale.

Atunci când bijuteriile nu sunt curăţate corespunzător, bacteriile cresc rapid. Dacă suntem obişnuiţi să ne atingem faţa de multe ori pe zi, este mai uşor pentru organismele nocive să se răspândească. În plus, atingem nu doar faţa, ci şi multe suprafeţe şi obiecte.
Cercetătorii au constatat că inelul a găzduit cinci specii bacteriene. Un total de 504 colonii bacteriene, o colonie de ciuperci şi o colonie de mucegai negru au fost găsite pe inel.
Pe locul doi, s-a aflat ceasul cu patru tipuri de microbi. În jur de 20.000 de colonii de bacterii s-au găsit pe ceas.
Un total de 485 de colonii bacteriene au fost găsite pe cercei. Cerceii găzduiau speciile Bacillus care erau prezente şi pe inel. Bacillus cereus este una dintre cele două specii patogene de bacil, care provoacă intoxicaţia alimentară la om dacă este ingerată.
Cum cureţi bijuteriile
Amestecă câteva picături de detergent de vase lichid în apă caldă (atât cât să acopere bijuteriile) şi lasă-le 30 de minute pentru a se înmuia. Umezeşte în soluţie o periuţă de dinţi şi începe să freci uşor podoabele, asigurându-te că ai pătruns prin fiecare gravură sau colţişor. Odată ce le-ai curăţat, le vei clăti cu apă rece. După ce ai clătit bine, foloseşte o cârpă moale uscată pentru a le lustrui. Pentru cele foarte murdare, repetă procesul cu soluţia şi cu limpezirea de mai multe ori.































